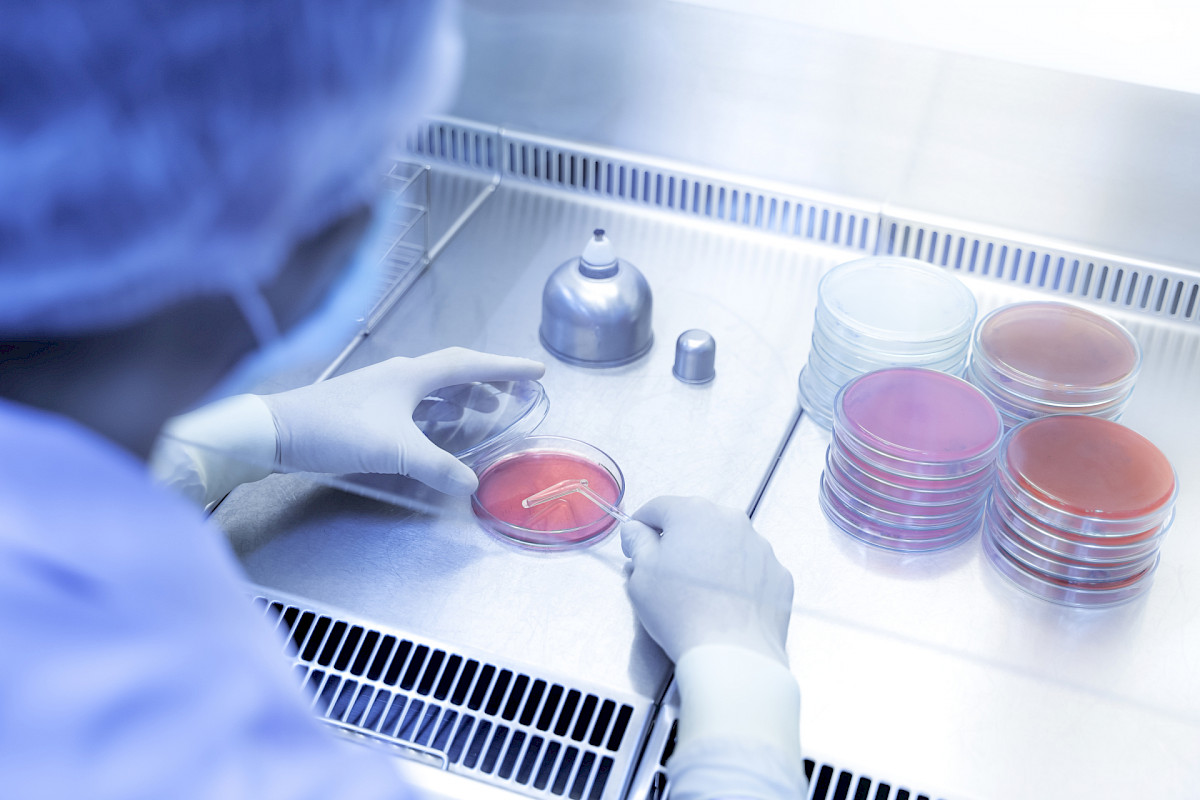

STM asetti koordinaatioryhmän koronaviruksen takia
Ryhmän tavoite on tehostaa johtamista ja toimenpiteiden koordinointia ministeriön toimialalla.
Sosiaali- ja terveysministeriö on asettanut kansanterveysuhkaan varautumista koordinoivan ryhmän, tiedottaa ministeriö. Ryhmä tulee tukemaan varautumista ja johtamista uuden koronaviruksen takia.
STM:n koordinaatioryhmän tehtävänä on suunnitella, johtaa ja yhteensovittaa uudesta koronaviruksesta aiheutuvia torjuntatoimenpiteitä sosiaali- ja terveydenhuollossa. Ryhmä tukee myös Terveyden ja hyvinvoinnin laitosta, Fimeaa, Valviraa, aluehallintovirastoa ja kuntien sekä kuntayhtymien viranomaisia näiden toiminnassa uhan torjumiseksi.
Koordinaatioryhmän alaisuudessa toimivan operatiivisen ryhmän tehtävänä on ylläpitää tilannekuvaa kentällä ja sovittaa yhteen varautumisen toimenpiteitä.
WHO on julistanut viruksen aiheuttaman epidemian kansainväliseksi kansanterveysuhaksi.